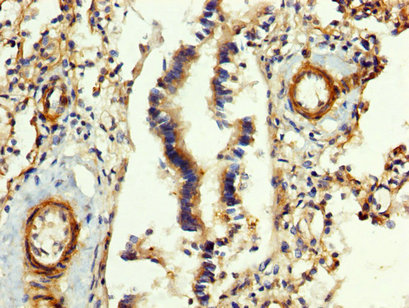
CSB-PA008608LA01HU

FGB
FGB,即纖維蛋白原β鏈。別名HEL-S-78p。它是由肝臟合成分泌的一種血漿蛋白,是血漿中濃度最高的凝血因子之一。FGB的作用機制涉及在血管損傷后,被凝血酶裂解形成纖維蛋白,這是血塊中最豐富的成分。纖維蛋白原和纖維蛋白的各種裂解產物調節細胞粘附和擴散,表現出血管收縮和趨化活性,并且是多種細胞類型的有絲分裂原。FGB在止血和抗菌宿主防御中起著關鍵作用,其基因的突變可能導致多種疾病,包括無纖維蛋白原血癥、異常纖維蛋白原血癥、低異常纖維蛋白原血癥和血栓形成傾向。
熱銷產品
Recombinant Human Fibrinogen beta chain (FGB), partial (CSB-EP008608HU)
驗證數據

(Tris-Glycine gel) Discontinuous SDS-PAGE (reduced) with 5% enrichment gel and 15% separation gel.

Based on the SEQUEST from database of E.coli host and target protein, the LC-MS/MS Analysis result of CSB-EP008608HU could indicate that this peptide derived from E.coli-expressed Homo sapiens (Human) FGB.

Based on the SEQUEST from database of E.coli host and target protein, the LC-MS/MS Analysis result of CSB-EP008608HU could indicate that this peptide derived from E.coli-expressed Homo sapiens (Human) FGB.
FGB Antibody (CSB-PA008608LA01HU)
驗證數據
IHC image of CSB-PA008608LA01HU diluted at 1:400 and staining in paraffin-embedded human lung tissue performed on a Leica BondTM system. After dewaxing and hydration, antigen retrieval was mediated by high pressure in a citrate buffer (pH 6.0). Section was blocked with 10% normal goat serum 30min at RT. Then primary antibody (1% BSA) was incubated at 4°C overnight. The primary is detected by a biotinylated secondary antibody and visualized using an HRP conjugated SP system.
Human Fibrinogen beta chain (FGB) ELISA kit (CSB-E09611h)
驗證數據

貨號:CSB-E09611h
規格:96T/48T
靈敏度: 0.11 ng/ml
檢測范圍:0.45 ng/ml-30 ng/ml
These standard curves are provided for demonstration only. A standard curve should be generated for each set of samples assayed.
FGB Antibodies
FGB for Homo sapiens (Human)
| 產品貨號 | 產品名稱 | 種屬反應性 | 應用類型 |
|---|---|---|---|
| CSB-PA265678 | FGB Antibody | Human | ELISA,WB |
| CSB-PA008236 | FGB Antibody | Human | WB, ELISA |
| CSB-PA237744 | FGB Antibody | Human,Mouse,Rat | ELISA,IHC |
| CSB-PA827609 | FGB Antibody | Human,Mouse,Rat | ELISA,WB,IHC |
| CSB-PA008608LA01HU | FGB Antibody | Human | ELISA, IHC |
| CSB-PA008608LB01HU | FGB Antibody, HRP conjugated | Human | ELISA |
| CSB-PA008608LC01HU | FGB Antibody, FITC conjugated | Human | |
| CSB-PA008608LD01HU | FGB Antibody, Biotin conjugated | Human | ELISA |
FGB Proteins
FGB Proteins for Equus asinus (Donkey)
| 產品貨號 | 產品名稱 | 來源 |
|---|---|---|
| CSB-YP008608DK CSB-EP008608DK CSB-BP008608DK CSB-MP008608DK CSB-EP008608DK-B |
Recombinant Donkey Fibrinogen beta chain (FGB) | Yeast E.coli Baculovirus Mammalian cell In Vivo Biotinylation in E.coli |
FGB Proteins for Capra hircus (Goat)
| 產品貨號 | 產品名稱 | 來源 |
|---|---|---|
| CSB-YP008608GO CSB-EP008608GO CSB-BP008608GO CSB-MP008608GO CSB-EP008608GO-B |
Recombinant Goat Fibrinogen beta chain (FGB) | Yeast E.coli Baculovirus Mammalian cell In Vivo Biotinylation in E.coli |
FGB Proteins for Ovis aries (Sheep)
| 產品貨號 | 產品名稱 | 來源 |
|---|---|---|
| CSB-YP008608SH CSB-EP008608SH CSB-BP008608SH CSB-MP008608SH CSB-EP008608SH-B |
Recombinant Sheep Fibrinogen beta chain (FGB) | Yeast E.coli Baculovirus Mammalian cell In Vivo Biotinylation in E.coli |
FGB Proteins for Equus caballus (Horse)
| 產品貨號 | 產品名稱 | 來源 |
|---|---|---|
| CSB-YP008608HO CSB-EP008608HO CSB-BP008608HO CSB-MP008608HO CSB-EP008608HO-B |
Recombinant Horse Fibrinogen beta chain (FGB), partial | Yeast E.coli Baculovirus Mammalian cell In Vivo Biotinylation in E.coli |
FGB Proteins for Sus scrofa (Pig)
| 產品貨號 | 產品名稱 | 來源 |
|---|---|---|
| CSB-YP008608PI CSB-EP008608PI CSB-BP008608PI CSB-MP008608PI CSB-EP008608PI-B |
Recombinant Pig Fibrinogen beta chain (FGB) | Yeast E.coli Baculovirus Mammalian cell In Vivo Biotinylation in E.coli |
FGB Proteins for Oryctolagus cuniculus (Rabbit)
| 產品貨號 | 產品名稱 | 來源 |
|---|---|---|
| CSB-YP008608RB CSB-EP008608RB CSB-BP008608RB CSB-MP008608RB CSB-EP008608RB-B |
Recombinant Rabbit Fibrinogen beta chain (FGB) | Yeast E.coli Baculovirus Mammalian cell In Vivo Biotinylation in E.coli |
FGB Proteins for Felis catus (Cat) (Felis silvestris catus)
| 產品貨號 | 產品名稱 | 來源 |
|---|---|---|
| CSB-YP008608CA CSB-BP008608CA CSB-MP008608CA CSB-EP008608CA-B |
Recombinant Cat Fibrinogen beta chain (FGB) | Yeast Baculovirus Mammalian cell In Vivo Biotinylation in E.coli |
FGB Proteins for Bos taurus (Bovine)
| 產品貨號 | 產品名稱 | 來源 |
|---|---|---|
| CSB-YP008608BO CSB-EP008608BO CSB-BP008608BO CSB-MP008608BO CSB-EP008608BO-B |
Recombinant Bovine Fibrinogen beta chain (FGB) | Yeast E.coli Baculovirus Mammalian cell In Vivo Biotinylation in E.coli |
FGB Proteins for Homo sapiens (Human)
| 產品貨號 | 產品名稱 | 來源 |
|---|---|---|
| CSB-YP008608HU CSB-BP008608HU CSB-MP008608HU CSB-EP008608HU-B |
Recombinant Human Fibrinogen beta chain (FGB), partial Yeast | Yeast Baculovirus Mammalian cell In Vivo Biotinylation in E.coli |
| CSB-EP008608HU | Recombinant Human Fibrinogen beta chain (FGB), partial | E.coli |
FGB Proteins for Canis familiaris (Dog) (Canis lupus familiaris)
| 產品貨號 | 產品名稱 | 來源 |
|---|---|---|
| CSB-YP008608DO CSB-EP008608DO CSB-BP008608DO CSB-MP008608DO CSB-EP008608DO-B |
Recombinant Dog Fibrinogen beta chain (FGB) | Yeast E.coli Baculovirus Mammalian cell In Vivo Biotinylation in E.coli |
FGB Proteins for Cervus elaphus (Red deer)
| 產品貨號 | 產品名稱 | 來源 |
|---|---|---|
| CSB-YP008608DRN CSB-EP008608DRN CSB-BP008608DRN CSB-MP008608DRN CSB-EP008608DRN-B |
Recombinant Cervus elaphus Fibrinogen beta chain (FGB) | Yeast E.coli Baculovirus Mammalian cell In Vivo Biotinylation in E.coli |
FGB Proteins for Camelus dromedarius (Dromedary) (Arabian camel)
| 產品貨號 | 產品名稱 | 來源 |
|---|---|---|
| CSB-YP008608CYV CSB-EP008608CYV CSB-BP008608CYV CSB-MP008608CYV CSB-EP008608CYV-B |
Recombinant Camelus dromedarius Fibrinogen beta chain (FGB) | Yeast E.coli Baculovirus Mammalian cell In Vivo Biotinylation in E.coli |
FGB Proteins for Cervus elaphus nelsoni (North American elk) (Cervus canadensis nelsoni)
| 產品貨號 | 產品名稱 | 來源 |
|---|---|---|
| CSB-YP008608CHB CSB-EP008608CHB CSB-BP008608CHB CSB-MP008608CHB CSB-EP008608CHB-B |
Recombinant Cervus elaphus nelsoni Fibrinogen beta chain (FGB) | Yeast E.coli Baculovirus Mammalian cell In Vivo Biotinylation in E.coli |
FGB Proteins for Lama vicugna (Vicugna) (Vicugna vicugna)
| 產品貨號 | 產品名稱 | 來源 |
|---|---|---|
| CSB-YP008608LBV CSB-EP008608LBV CSB-BP008608LBV CSB-MP008608LBV CSB-EP008608LBV-B |
Recombinant Lama vicugna Fibrinogen beta chain (FGB) | Yeast E.coli Baculovirus Mammalian cell In Vivo Biotinylation in E.coli |
FGB Proteins for Lama glama (Llama)
| 產品貨號 | 產品名稱 | 來源 |
|---|---|---|
| CSB-YP008608LBS CSB-EP008608LBS CSB-BP008608LBS CSB-MP008608LBS CSB-EP008608LBS-B |
Recombinant Lama glama Fibrinogen beta chain (FGB) | Yeast E.coli Baculovirus Mammalian cell In Vivo Biotinylation in E.coli |
FGB Proteins for Muntiacus muntjak (Barking deer) (Indian muntjac)
| 產品貨號 | 產品名稱 | 來源 |
|---|---|---|
| CSB-YP008608MJP CSB-EP008608MJP CSB-BP008608MJP CSB-MP008608MJP CSB-EP008608MJP-B |
Recombinant Muntiacus muntjak Fibrinogen beta chain (FGB) | Yeast E.coli Baculovirus Mammalian cell In Vivo Biotinylation in E.coli |
FGB Proteins for Vulpes vulpes (Red fox)
| 產品貨號 | 產品名稱 | 來源 |
|---|---|---|
| CSB-YP008608VFW CSB-EP008608VFW CSB-BP008608VFW CSB-MP008608VFW CSB-EP008608VFW-B |
Recombinant Vulpes vulpes Fibrinogen beta chain (FGB) | Yeast E.coli Baculovirus Mammalian cell In Vivo Biotinylation in E.coli |
FGB Proteins for Elephas maximus (Indian elephant)
| 產品貨號 | 產品名稱 | 來源 |
|---|---|---|
| CSB-YP008608EKA CSB-EP008608EKA CSB-BP008608EKA CSB-MP008608EKA CSB-EP008608EKA-B |
Recombinant Elephas maximus Fibrinogen beta chain (FGB) | Yeast E.coli Baculovirus Mammalian cell In Vivo Biotinylation in E.coli |
FGB Proteins for Anas platyrhynchos (Domestic duck) (Anas boschas)
| 產品貨號 | 產品名稱 | 來源 |
|---|---|---|
| CSB-YP008608BZD CSB-EP008608BZD CSB-BP008608BZD CSB-MP008608BZD CSB-EP008608BZD-B |
Recombinant Anas platyrhynchos Fibrinogen beta chain (FGB) | Yeast E.coli Baculovirus Mammalian cell In Vivo Biotinylation in E.coli |
FGB Proteins for Antilocapra americana (Pronghorn)
| 產品貨號 | 產品名稱 | 來源 |
|---|---|---|
| CSB-YP008608ALS CSB-EP008608ALS CSB-BP008608ALS CSB-MP008608ALS CSB-EP008608ALS-B |
Recombinant Antilocapra americana Fibrinogen beta chain (FGB) | Yeast E.coli Baculovirus Mammalian cell In Vivo Biotinylation in E.coli |
FGB Proteins for Bubalus bubalis (Domestic water buffalo)
| 產品貨號 | 產品名稱 | 來源 |
|---|---|---|
| CSB-YP008608BWX CSB-EP008608BWX CSB-BP008608BWX CSB-MP008608BWX CSB-EP008608BWX-B |
Recombinant Bubalus bubalis Fibrinogen beta chain (FGB) | Yeast E.coli Baculovirus Mammalian cell In Vivo Biotinylation in E.coli |
FGB Proteins for Hylobates lar (Common gibbon)
| 產品貨號 | 產品名稱 | 來源 |
|---|---|---|
| CSB-YP008608HXW CSB-EP008608HXW CSB-BP008608HXW CSB-MP008608HXW CSB-EP008608HXW-B |
Recombinant Hylobates lar Fibrinogen beta chain (FGB) | Yeast E.coli Baculovirus Mammalian cell In Vivo Biotinylation in E.coli |
FGB Proteins for Rattus norvegicus (Rat)
| 產品貨號 | 產品名稱 | 來源 |
|---|---|---|
| CSB-YP008608RA CSB-EP008608RA CSB-BP008608RA CSB-MP008608RA CSB-EP008608RA-B |
Recombinant Rat Fibrinogen beta chain (Fgb) | Yeast E.coli Baculovirus Mammalian cell In Vivo Biotinylation in E.coli |
FGB Proteins for Ceratotherium simum (White rhinoceros) (Square-lipped rhinoceros)
| 產品貨號 | 產品名稱 | 來源 |
|---|---|---|
| CSB-YP008608DRG CSB-EP008608DRG CSB-BP008608DRG CSB-MP008608DRG CSB-EP008608DRG-B |
Recombinant Ceratotherium simum Fibrinogen beta chain (FGB) | Yeast E.coli Baculovirus Mammalian cell In Vivo Biotinylation in E.coli |
FGB Proteins for Tapirus terrestris (Lowland tapir) (Brazilian tapir)
| 產品貨號 | 產品名稱 | 來源 |
|---|---|---|
| CSB-YP008608TLG CSB-EP008608TLG CSB-BP008608TLG CSB-MP008608TLG CSB-EP008608TLG-B |
Recombinant Tapirus terrestris Fibrinogen beta chain (FGB) | Yeast E.coli Baculovirus Mammalian cell In Vivo Biotinylation in E.coli |
FGB Proteins for Bison bonasus (European bison)
| 產品貨號 | 產品名稱 | 來源 |
|---|---|---|
| CSB-YP008608BTF CSB-EP008608BTF CSB-BP008608BTF CSB-MP008608BTF CSB-EP008608BTF-B |
Recombinant Bison bonasus Fibrinogen beta chain (FGB) | Yeast E.coli Baculovirus Mammalian cell In Vivo Biotinylation in E.coli |
FGB Proteins for Mandrillus leucophaeus (Drill) (Papio leucophaeus)
| 產品貨號 | 產品名稱 | 來源 |
|---|---|---|
| CSB-YP008608MBX CSB-EP008608MBX CSB-BP008608MBX CSB-MP008608MBX CSB-EP008608MBX-B |
Recombinant Mandrillus leucophaeus Fibrinogen beta chain (FGB) | Yeast E.coli Baculovirus Mammalian cell In Vivo Biotinylation in E.coli |
FGB Proteins for Odocoileus hemionus (Mule deer) (Black-tailed deer)
| 產品貨號 | 產品名稱 | 來源 |
|---|---|---|
| CSB-YP008608OAJ CSB-EP008608OAJ CSB-BP008608OAJ CSB-MP008608OAJ CSB-EP008608OAJ-B |
Recombinant Odocoileus hemionus Fibrinogen beta chain (FGB) | Yeast E.coli Baculovirus Mammalian cell In Vivo Biotinylation in E.coli |
FGB Proteins for Rangifer tarandus (Reindeer) (Cervus tarandus)
| 產品貨號 | 產品名稱 | 來源 |
|---|---|---|
| CSB-YP008608RBL CSB-EP008608RBL CSB-BP008608RBL CSB-MP008608RBL CSB-EP008608RBL-B |
Recombinant Rangifer tarandus Fibrinogen beta chain (FGB) | Yeast E.coli Baculovirus Mammalian cell In Vivo Biotinylation in E.coli |
FGB Proteins for Syncerus caffer (Cape buffalo)
| 產品貨號 | 產品名稱 | 來源 |
|---|---|---|
| CSB-YP008608FPX CSB-EP008608FPX CSB-BP008608FPX CSB-MP008608FPX CSB-EP008608FPX-B |
Recombinant Syncerus caffer Fibrinogen beta chain (FGB) | Yeast E.coli Baculovirus Mammalian cell In Vivo Biotinylation in E.coli |
FGB Proteins for Macaca fuscata fuscata (Japanese macaque)
| 產品貨號 | 產品名稱 | 來源 |
|---|---|---|
| CSB-YP008608MMX CSB-EP008608MMX CSB-BP008608MMX CSB-MP008608MMX CSB-EP008608MMX-B |
Recombinant Macaca fuscata fuscata Fibrinogen beta chain (FGB) | Yeast E.coli Baculovirus Mammalian cell In Vivo Biotinylation in E.coli |
FGB Proteins for Erythrocebus patas (Red guenon) (Cercopithecus patas)
| 產品貨號 | 產品名稱 | 來源 |
|---|---|---|
| CSB-YP008608EGU CSB-EP008608EGU CSB-BP008608EGU CSB-MP008608EGU CSB-EP008608EGU-B |
Recombinant Erythrocebus patas Fibrinogen beta chain (FGB) | Yeast E.coli Baculovirus Mammalian cell In Vivo Biotinylation in E.coli |
FGB Proteins for Papio anubis (Olive baboon)
| 產品貨號 | 產品名稱 | 來源 |
|---|---|---|
| CSB-YP008608ERI CSB-EP008608ERI CSB-BP008608ERI CSB-MP008608ERI CSB-EP008608ERI-B |
Recombinant Papio anubis Fibrinogen beta chain (FGB) | Yeast E.coli Baculovirus Mammalian cell In Vivo Biotinylation in E.coli |
FGB Proteins for Theropithecus gelada (Gelada baboon)
| 產品貨號 | 產品名稱 | 來源 |
|---|---|---|
| CSB-YP008608TNU CSB-EP008608TNU CSB-BP008608TNU CSB-MP008608TNU CSB-EP008608TNU-B |
Recombinant Theropithecus gelada Fibrinogen beta chain (FGB) | Yeast E.coli Baculovirus Mammalian cell In Vivo Biotinylation in E.coli |
FGB Proteins for Papio hamadryas (Hamadryas baboon)
| 產品貨號 | 產品名稱 | 來源 |
|---|---|---|
| CSB-YP008608ERJ CSB-EP008608ERJ CSB-BP008608ERJ CSB-MP008608ERJ CSB-EP008608ERJ-B |
Recombinant Papio hamadryas Fibrinogen beta chain (FGB) | Yeast E.coli Baculovirus Mammalian cell In Vivo Biotinylation in E.coli |
FGB Proteins for Mus musculus (Mouse)
| 產品貨號 | 產品名稱 | 來源 |
|---|---|---|
| CSB-YP008608MO CSB-EP008608MO CSB-BP008608MO CSB-MP008608MO CSB-EP008608MO-B |
Recombinant Mouse Fibrinogen beta chain (Fgb) | Yeast E.coli Baculovirus Mammalian cell In Vivo Biotinylation in E.coli |
FGB ELISA Kit
FGB ELISA Kit for Homo sapiens (Human)
| 產品貨號 | 產品名稱 | 樣本類型 | 靈敏度 |
|---|---|---|---|
| CSB-E09611h | Human Fibrinogen beta chain (FGB) ELISA kit | serum, plasma, tissue homogenates | 0.11 ng/ml |











